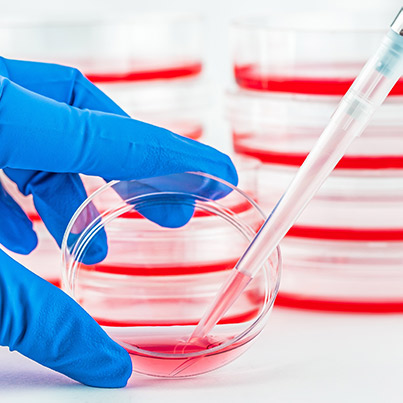

Albumin Fusion Protein Production Services
As biopharmaceutical innovation accelerates, the demand for next-generation biologics with improved pharmacokinetics and patient outcomes is growing rapidly. In particular, albumin fusion protein technologies are gaining traction as a powerful strategy to overcome the limitations of short-lived therapeutic proteins by extending their half-life, enhancing stability, and reducing dosing frequency. These advances are critical across fields such as drug delivery, chimeric protein therapeutics, and long-acting biologics.
At Creative BioMart , we meet this demand with comprehensive Albumin Fusion Protein Production Services —offering seamless solutions from gene to purified fusion protein. Leveraging optimized mammalian expression systems , proprietary purification matrices, and scalable production capabilities, we empower researchers and developers with high-quality, animal-free albumin fusion proteins tailored to their exact specifications. Experience a streamlined path from concept to final product—engineered for efficiency, precision, and performance.

Background: Why Choose Albumin Fusion for Protein Therapeutics
Albumin fusion proteins are created by genetically fusing therapeutic peptides or proteins to human serum albumin (HSA). Native HSA’s 20-day half-life, conferred by pH-dependent recycling via the neonatal Fc receptor (FcRn), is exploited to extend the half-life of the fused cargo. A single open reading frame encoding albumin followed (or preceded) by the active peptide is expressed in microbial, yeast, or mammalian hosts. The secreted fusion is purified by standard chromatography, yielding >90 % purity without additional chemical conjugation or animal-derived components.
Key Benefits of Albumin Fusion Technology
- Extended Half-Life
Fusing therapeutic proteins to albumin dramatically increases their circulating half-life—from minutes or hours to several days or even weeks—significantly reducing dosing frequency and improving patient adherence in long-term treatments.
- Enhanced Stability
Albumin acts as a protective carrier, shielding the fused therapeutic domain from enzymatic degradation, aggregation, and denaturation—resulting in lower immunogenicity and greater in vivo functional stability across diverse conditions.
- Simple, Scalable Production
Albumin fusion constructs are genetically encoded and expressed in high-yield systems like yeast or mammalian cells, achieving titers >5 g/L in single-step fermentation without the need for PEGylation or chemical linkers.
- Regulatory Familiarity
With FDA- and EMA-approved drugs like albiglutide and etanercept as precedents, albumin fusion proteins benefit from a well-understood regulatory pathway—helping to de-risk development and accelerate timelines to IND/clinical trials.
- Cost-Effective Manufacturing
High expression yields combined with compatibility with standard purification platforms, such as affinity or ion-exchange chromatography , allow for lower cost-of-goods and efficient large-scale production without complex or proprietary reagents.
Application Areas of Albumin Fusion Proteins
- Metabolic Disorders
Albumin fusion enhances the pharmacokinetics of therapeutic hormones like GLP-1 , insulin , and growth hormone, enabling long-acting formulations for improved management of diabetes, obesity, and growth hormone deficiencies with fewer injections.
- Oncology
Fusing interleukin-2 , interferon-α , or antibody fragments with albumin increases their half-life and tumor-targeting efficiency, offering a promising approach for treating solid tumors and blood cancers with sustained immune modulation.
- Hematology
Albumin-fused clotting factors such as factor VIII and IX , as well as thrombopoietin analogues, support long-term treatment of hemophilia and thrombocytopenia by extending circulation time and reducing dosing frequency.
- Immunology
Engineered albumin-scFv and albumin-nanobody fusion proteins offer targeted immunomodulation for autoimmune diseases and transplant rejection, with extended half-life and tissue-specific biodistribution enhancing therapeutic control and patient compliance.
- Antimicrobial and Vaccine Applications
Albumin-fused antigens or antimicrobial peptides provide improved immunogenicity and bioavailability, making them effective candidates for infectious disease vaccines and therapeutics with enhanced stability and prolonged systemic presence.
- Ag-Biotech
In agricultural biotechnology, albumin-lectin fusion proteins act as potent, long-acting bioinsecticides, remaining in insect midguts longer to disrupt feeding and development—reducing pesticide use and enhancing crop protection.
Figure 1. Structure model of fusion proteins, Mb‐HSA and ZnMb-HSA: Mb unit (PDB ID 3RGK), red; HSA unit (PDB ID 1BJ5), green; heme in the Mb unit, gray. (Yamada et al ., 2023)
Our Albumin Fusion Protein Production Services
Service Procedure: From Gene to Fusion Protein

Service Details at a Glance
-

Production Scale
µg to kg, scalable, one protocol from R&D to pre-clinical.
-
Expression
CHO/HEK293, human-like PTMs, high yield, regulatory-ready.
-

Purification
Custom flow; proprietary albumin resin boosts purity/bioactivity; endotoxin control.
-

Construct Design
N- or C-terminal albumin, variable linkers, detection tags optimized for stability.
-

Quality Control
SDS-PAGE, WB, ELISA, HPLC, MS, endotoxin; full report per batch.
-

Timeline & Support
6–10 weeks; dedicated tech contact, milestone updates.
Key Advantages of Our Albumin Fusion Services
- Exclusive Albumin Fusion Binding Matrices : We offer specialized purification platforms designed specifically for albumin fusion constructs, delivering higher purity and yield with reduced downstream complexity.
- Fully Animal-Free Production Workflow : Our entire process—from gene to purified protein—is animal-component-free, ensuring compliance with global regulatory standards.
- One-Stop, Gene-to-Protein Solutions : Creative BioMart streamlines your project with complete in-house capabilities: vector design, expression in mammalian cells, scale-up, purification, and QC.
- Scalability from Microgram to Kilogram : Whether you’re prototyping a novel construct or preparing for preclinical studies, we scale your production seamlessly—without compromising quality or timeline.
- Tailored to Your Targets : We understand the nuances of albumin fusion—N- or C-terminal fusions, linker optimization, and co-expression strategies. Your project isn’t cookie-cutter, and neither are our solutions.
Case Highlights in Albumin Fusion Protein Engineering
* NOTE: We prioritize confidentiality to safeguard our clients’ technology and intellectual property. As an alternative, we present selected published research articles as representative case studies. For details on the assay services and products used in these studies, please refer to the relevant sections of the cited literature.
Case 1: Albumin fusion of interleukin-28B
Zhao et al. , 2013. doi:10.1371/journal.pone.0064301
Interleukin-28B (IL-28B) has antiviral and immune-regulating functions, with genetic variants linked to hepatitis C treatment response. In this study, IL-28B was fused to human serum albumin (HSA) and expressed in yeast. The N-terminal HSA-IL28B fusion retained bioactivity, showed enhanced stability, and effectively inhibited HCV infection via IL28R1 and IL10R2 receptors. It also activated interferon-stimulated genes and STAT1 phosphorylation in specific cell types. These results suggest strong clinical potential for HSA-IL28B in antiviral therapies and immune modulation.
Figure 2. HSA-IL28B demonstrates antiviral activity against HCV and improved protein stability. (A) HCV-infected Huh7.5.1 cells were treated with N-HSA-IL28B or IL28B-HSA-C. (B) Native IL-28B and N-HSA-IL28B were incubated at 37 °C; activity assessed in HCV-infected cells. (C) Serial dilutions of IL-28B variants were incubated at 37 °C; antiviral activity evaluated by luciferase readout. (Zhao et al ., 2013)
Case 2: Albumin and interferon-β fusion protein serves as an effective vaccine adjuvant
Tseng et al ., 2022. doi:10.1136/jitc-2021-004342
This study explores the fusion of albumin to interferon-β (Alb-IFNβ) to enhance its stability and immunotherapeutic potential. Alb-IFNβ retained full biological activity and significantly extended IFNβ’s half-life in serum, lymph nodes, and tumors. When co-administered with antigenic peptides like OVA or HPV E7, Alb-IFNβ boosted antigen-specific CD8+ T cell responses and exhibited strong antitumor effects in a TC-1 tumor model. The therapeutic efficacy depended on CD8+ T cells and dendritic cells. Alb-IFNβ also served as a powerful adjuvant for the HPV vaccine TA-CIN.
Figure 3. Analysis of Alb-IFNβ half-life within the C57BL/6 or FcRn knockout mice. (A) IFNβ or Alb-IFNβ was injected into naïve C57BL/6 or FcRn KO mice. (B) IFNβ or Alb-IFNβ was injected into naïve mice; lymph nodes were collected after 16 hours and analyzed by ELISA. (C) Tumor-bearing mice were treated with IFNβ or Alb-IFNβ; tumors and tumor-draining lymph nodes were harvested at 16 hours for IFNβ detection. (Tseng et al ., 2022)
Client Experiences with Our Albumin Fusion Protein Production Services
"Creative BioMart delivered exactly what we needed: a high-purity N-terminal albumin fusion of our therapeutic enzyme for metabolic disorder research. The extended half-life results exceeded our preclinical expectations, and the yield was phenomenal—over 4 g/L in CHO cells. Their technical team was incredibly responsive, and the one-stop workflow saved us months in development."
— R&D Director | Mid-Sized Biopharma Company
"We partnered with Creative BioMart to produce an albumin-IL-2 fusion protein for a solid tumor immunotherapy candidate. Their ability to optimize expression and fine-tune linker length really impressed us. The protein was highly stable and retained bioactivity throughout animal studies. Their QC documentation was thorough and regulatory-ready."
— Principal Scientist | Oncology Therapeutics Startup
"Our client needed a C-terminal albumin fusion of a nanobody for autoimmune disease studies—on a tight timeline. Creative BioMart not only delivered ahead of schedule but provided excellent technical insight into fusion orientation and construct design. The final product showed exceptional solubility and was completely animal-free, which made it ideal for early preclinical use."
— Senior Project Manager | Global CRO
"We were looking for a durable albumin-lectin fusion protein for oral delivery in pest-resistant crops. Creative BioMart nailed it with scalable expression in yeast and >5 g/L yield. Their team helped us refine the fusion strategy for optimal gut retention in target insects. Very pleased with the professionalism and technical depth of their support."
— Head of Bioprocessing | Agricultural Biotech Firm
Frequently Asked Questions–Albumin Fusion Protein Production Services
-
Q: What expression systems do you use for albumin fusion proteins, and why?
A: We primarily use mammalian systems like CHO and HEK293 cells to ensure proper protein folding, post-translational modifications, and bioactivity. These are industry-standard systems for therapeutic-grade proteins and offer scalable, high-yield expression. -
Q: Can you help design the albumin fusion construct (e.g., linker, orientation)?
A: Absolutely. We provide end-to-end construct design, including guidance on N- or C-terminal fusions, linker optimization, and affinity tags. Our experts help maximize protein stability, solubility, and bioactivity tailored to your specific research goals. -
Q: What production scales are available?
A: We offer a full range—from microgram quantities for discovery-phase work to kilogram-scale batches for preclinical and commercial development. Our scalable processes ensure consistent quality at any volume. -
Q: How long does the albumin fusion protein production process take?
A: Our typical turnaround time is 6 to 10 weeks, depending on construct complexity and production scale. You'll receive regular progress updates and access to dedicated technical support throughout the project. -
Q: Do you use animal-free production methods?
A: Yes, our entire workflow—from gene cloning to purification—is 100% animal-free, making our albumin fusion proteins ideal for therapeutic use and regulatory submissions where animal component-free materials are required. -
Q: What purification methods do you use?
A: We utilize both customized protocols and proprietary albumin-binding matrices for efficient, high-purity purification. This approach helps retain protein function while streamlining downstream processing, even at large scales. -
Q: How do you ensure product quality and consistency?
A: Every batch undergoes a comprehensive QC panel, including SDS-PAGE, Western blot, ELISA, HPLC, mass spectrometry, and optional endotoxin testing. You’ll receive a full report detailing identity, purity, concentration, and activity data.
Resources
Related Services
- Fc Fusion Protein Production
- Protein Engineering Services
- Bacterial Expression Systems (E. coli / Bacillus)
- Yeast Expression Systems
- Mammalian Expression Systems
- High Yield Protein Production
- High-throughput Protein Production
- Serum-Free Expression System
- Protein Expression and Purification Services
Related Products
References:
- Kulakova A, Indrakumar S, Sønderby Tuelung P, et al . Albumin-neprilysin fusion protein: understanding stability using small angle X-ray scattering and molecular dynamic simulations. Sci Rep . 2020;10(1):10089. doi:10.1038/s41598-020-67002-9
- Tseng SH, Cheng MA, Farmer E, et al . Albumin and interferon-β fusion protein serves as an effective vaccine adjuvant to enhance antigen-specific CD8+ T cell-mediated antitumor immunity. J Immunother Cancer . 2 022;10(4):e004342. doi:10.1136/jitc-2021-004342
- Varanko A, Saha S, Chilkoti A. Recent trends in protein and peptide-based biomaterials for advanced drug delivery. Advanced Drug Delivery Reviews . 2020;156:133-187. doi:10.1016/j.addr.2020.08.008
- Wang S, Liu S, Zhang Y, He J, Coy DH, et al . Human Serum Albumin (HSA) and Its Applications as a Drug Delivery Vehicle. Health Sci J . 2020;14:2. doi:10.36648/1791-809X.14.2.698
- Yamada T, Morita Y, Takada R, et al . Zinc substituted myoglobin−albumin fusion protein: a photosensitizer for cancer therapy. Chemistry A European J . 2023;29(22):e202203952. doi:10.1002/chem.202203952
- Zhao J, Si Y, Cheng M, et al . Albumin fusion of interleukin-28B: production and characterization of its biological activities and protein stability. Choi J, ed. PLoS ONE . 2013;8(5):e64301. doi:10.1371/journal.pone.0064301
Contact us or send an email at for project quotations and more detailed information.
Quick Links
-
Papers’ PMID to Obtain Coupon
Submit Now -
Refer Friends & New Lab Start-up Promotions